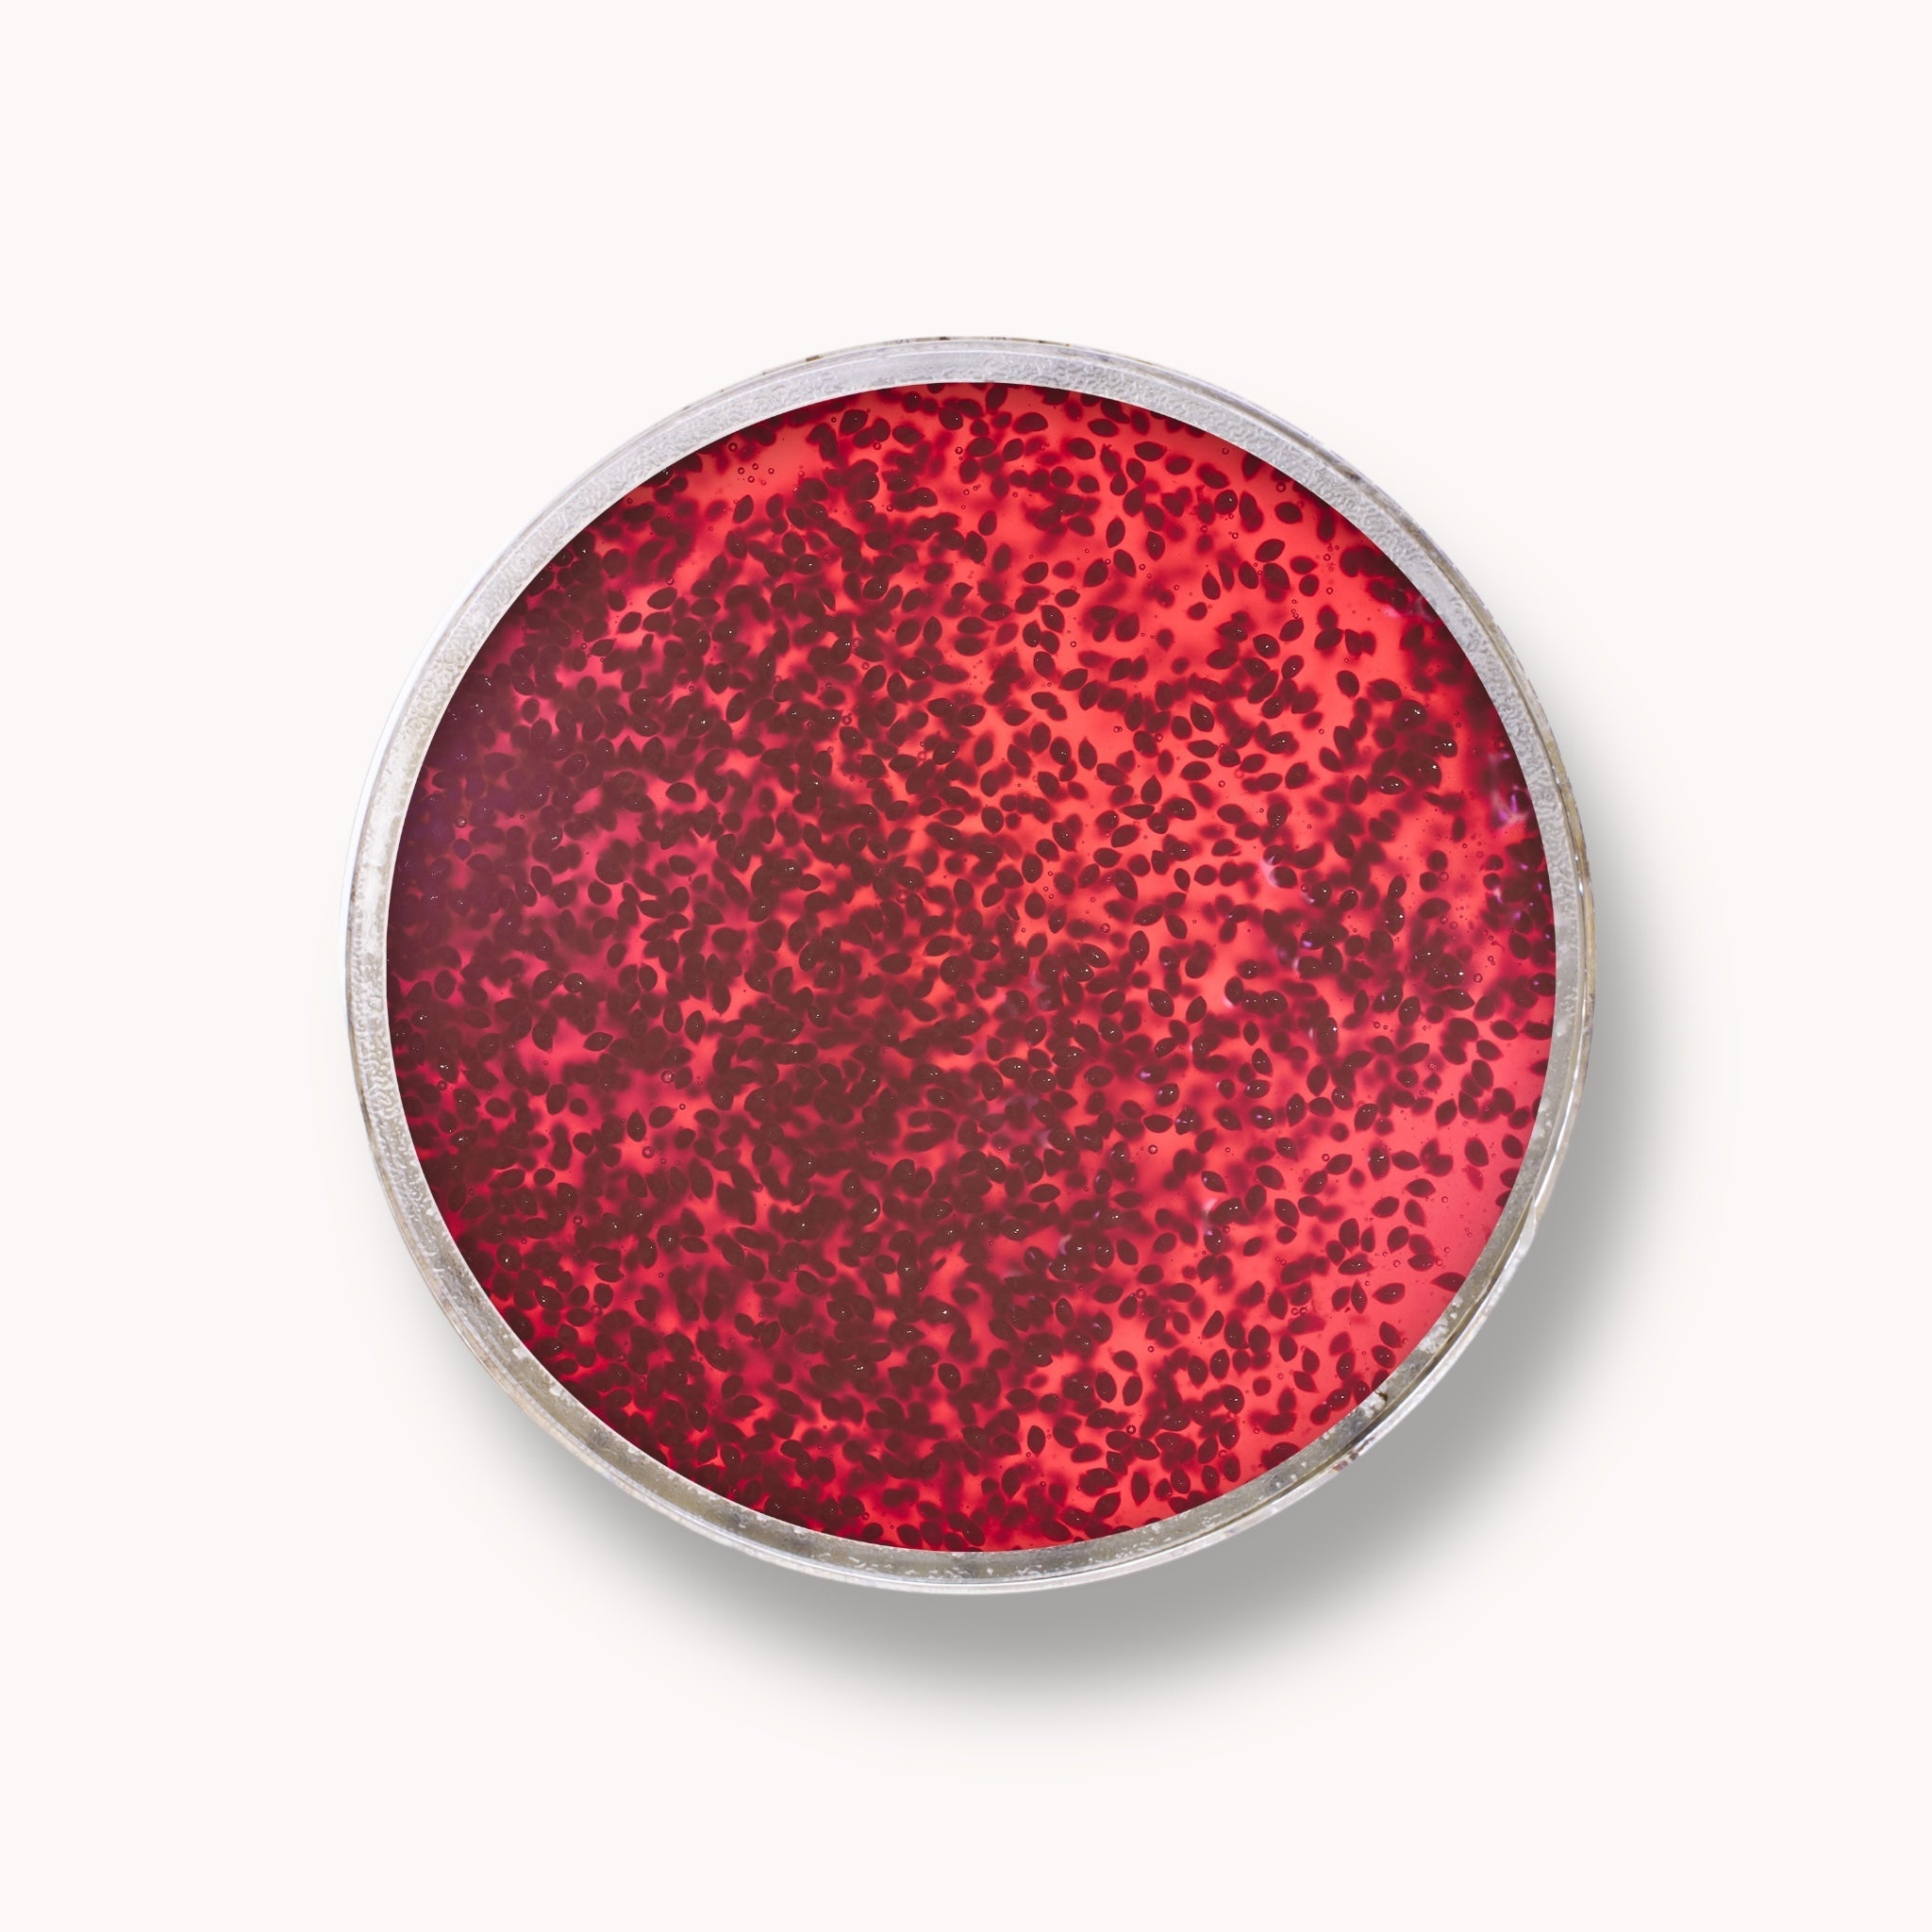

Sugar Jelly Scrub - Cranberries
64360
- Regular price
-
€22,95 - Sale price
-
€22,95 - Regular price
-
€0
96.7% natural ingredients. Discover the magic of the sugar scrub, a true delight for the senses! Its jelly-like texture embraces the skin, transforming your skincare routine into a luxurious experience. The delicate sugar granules and cranberry seeds come together in an exfoliating dance, deeply cleansing and hydrating the skin. The result? Silky, radiant, and incredibly smooth skin, ready to shine in the daylight.
Free from parabens. Not tested on animals.
200 g
KEY INGREDIENTS
- Sugar – Gently exfoliates the skin, removes dead cells, and helps maintain hydration, leaving the skin soft and smooth.
- Cranberry Seeds – Rich in antioxidants, they provide gentle exfoliation, help improve skin texture, and protect the skin from environmental damage.
USAGE
Apply a small amount to the skin and gently massage in circular motions. Feel the granules cleanse and revitalize every inch of your body. Then, rinse with water and enjoy skin that is brighter, healthier, and more radiant than ever. Let your skin breathe and glow with joy every moment!
BENEFITS
Less is more. In general, we tend to agree with this principle. However, when it comes to your pampering moments, nothing is too much.
Complete your healthy skincare routine with:
Body Butter (rich texture, recommended for very dry skin),
Body Sorbet (light texture, fast absorption, suitable for all skin types),
Dry Body Oil (absorbs quickly into the skin, leaving it smooth and silky),
Body Cream (creamy texture, fast absorption, optimal hydration).
INGREDIENTS
Sucrose (Sugar), Glycerin, Aqua (Water), Polysorbate 20, Vaccinium Macrocarpon (Cranberry) Seed, Parfum, Glyceryl Polyacrylate, Phenoxyethanol, Ethylhexylglycerin, Benzyl Alcohol, Linalool, CI14720

Sugar Jelly Scrub - Cranberries
- Regular price
-
€22,95 - Sale price
-
€22,95 - Regular price
-
€0
It smells gorgeous!